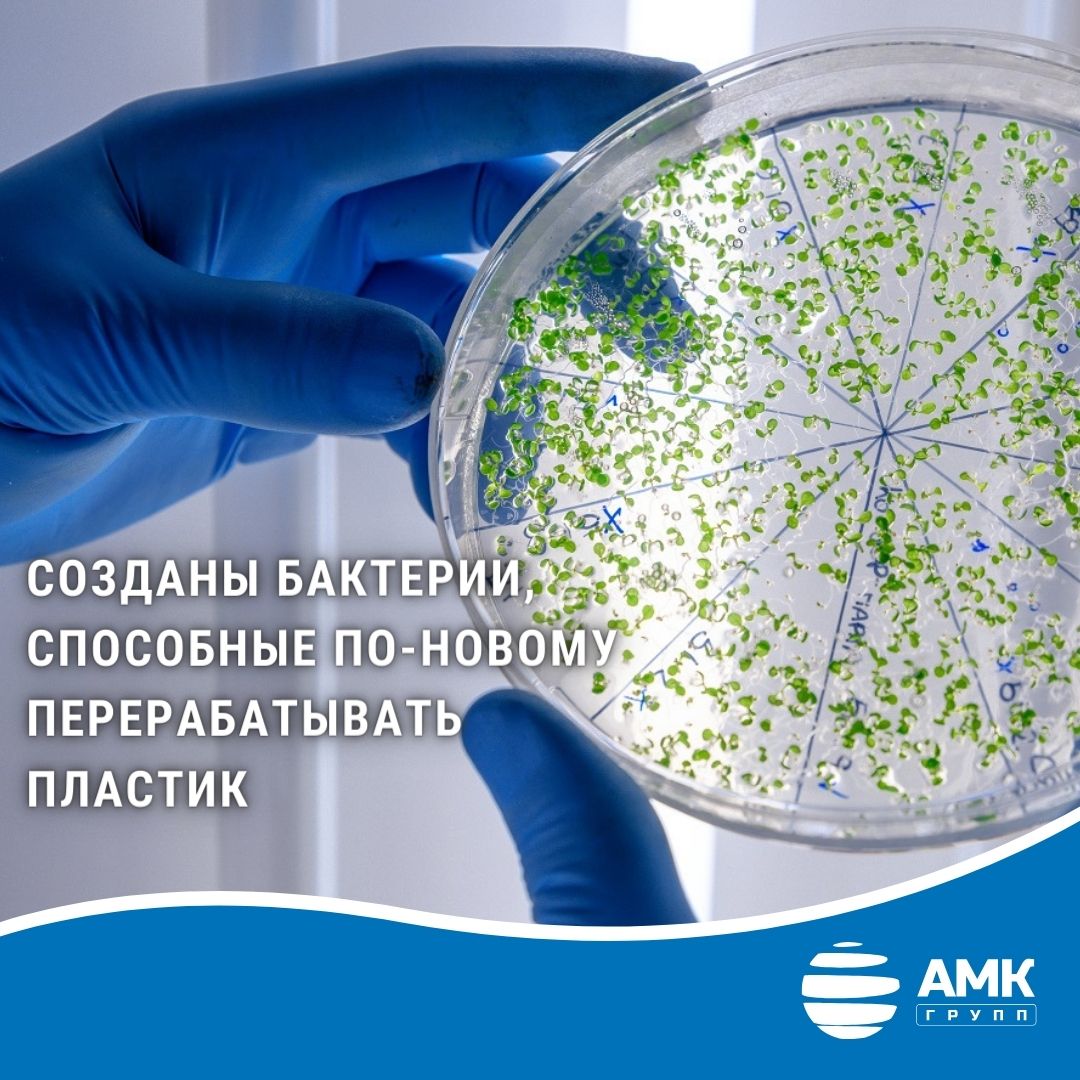

Биоразлагаемый пластик вышел на новый уровень?!
Для этого исследователи из Университета Кобе и компании Kaneka Corporation взяли полимолочную кислоту. Сейчас ее активно используют для производства одноразовой посуды, пищевой упаковки и других одноразовых изделий. Но сам по себе материал достаточно хрупкий и плохо разлагается.
Биоинженеры соединили полимолочную кислоту с биопластиком под названием LAHB и получили новый высокопрозрачный материал. Он лучше поддается обработке, чем чистая полимолочная кислота, более ударопрочен и разлагается в морской воде за неделю.
«Смешивая полимолочную кислоту с LAHB, можно одним махом преодолеть многочисленные проблемы полимолочной кислоты, и ожидается, что модифицированный таким образом материал станет экологически устойчивым биопластиком, удовлетворяющим противоречивые потребности в физической прочности и биоразлагаемости», — пояснил руководитель проекта Сейичи Тагучи.
Однако ученые мечтают о большем. Штамм бактерий, который они использовали, способен употреблять CO2 в качестве сырья. А значит, в теории можно синтезировать полезные пластики непосредственно из парникового газа, тем самым значительно снизив экологическую нагрузку на планету.
Что ж, в ближайшем будущем ожидаем новостей про «зеленое» производство пластика!